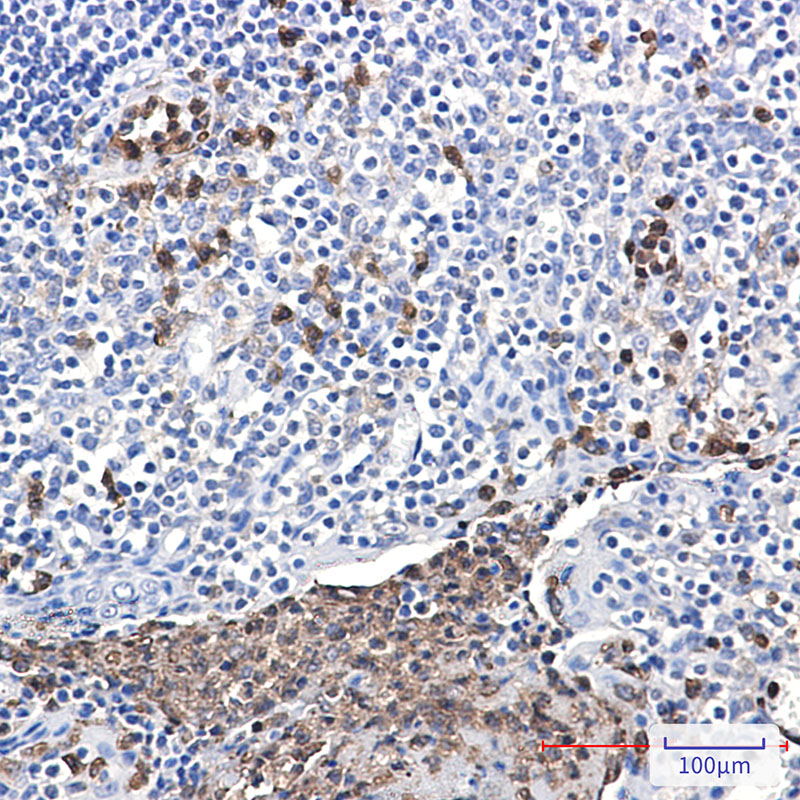

-
分类: 科研抗体货号: P22496别名: NPAP60; NPAP60L应用: WB,IF反应种属: Human,Rat
-
分类: 科研抗体货号: P22497别名: 96 kDa nucleoporin; 98 kDa nucleoporin; ADAR2; ADIR2; GLFG-repeat containing nucleoporin; Nuclear pore complex protein Nup96; Nuclear pore complex protein Nup98 Nup96; Nucleoporin 98kD; nucleoporin 98kDa; Nucleoporin Nup96; Nucleoporin Nup98; NUP196; NUP9应用: WB反应种属: Human
-
分类: 科研抗体货号: P22495别名: NPAP60; NPAP60L应用: WB,IP,IF反应种属: Human
-
分类: 科研抗体货号: P22510别名: PXN; Paxillin应用: WB,IP,IHC反应种属: Human,Rat,Hamster
-
分类: 科研抗体货号: P22494别名: N155; ATFB15应用: WB,IF反应种属: Human
-
分类: 科研抗体货号: P22509别名: PAWR; PAR4; PRKC apoptosis WT1 regulator protein; Prostate apoptosis response 4 protein; Par-4应用: WB,IP反应种属: Human,Mouse
-
分类: 科研抗体货号: P22493别名: ODG6; NUP84; NPHS11; ODG6; GAMOS7应用: WB,IP反应种属: Human
-
分类: 科研抗体货号: P22508别名: CDKN1C; KIP2; Cyclin-dependent kinase inhibitor 1C; Cyclin-dependent kinase inhibitor p57; p57Kip2应用: WB,IP,IHC反应种属: Human
-
分类: 科研抗体货号: P22492别名: C23; Nsr1应用: WB,IP反应种属: Human
-
分类: 科研抗体货号: P22507别名: NCF; CGD3; P40PHOX; SH3PXD4应用: WB,IP,IHC,IF反应种属: Human

鄂公网安备42018502007531号
鄂公网安备42018502007531号

